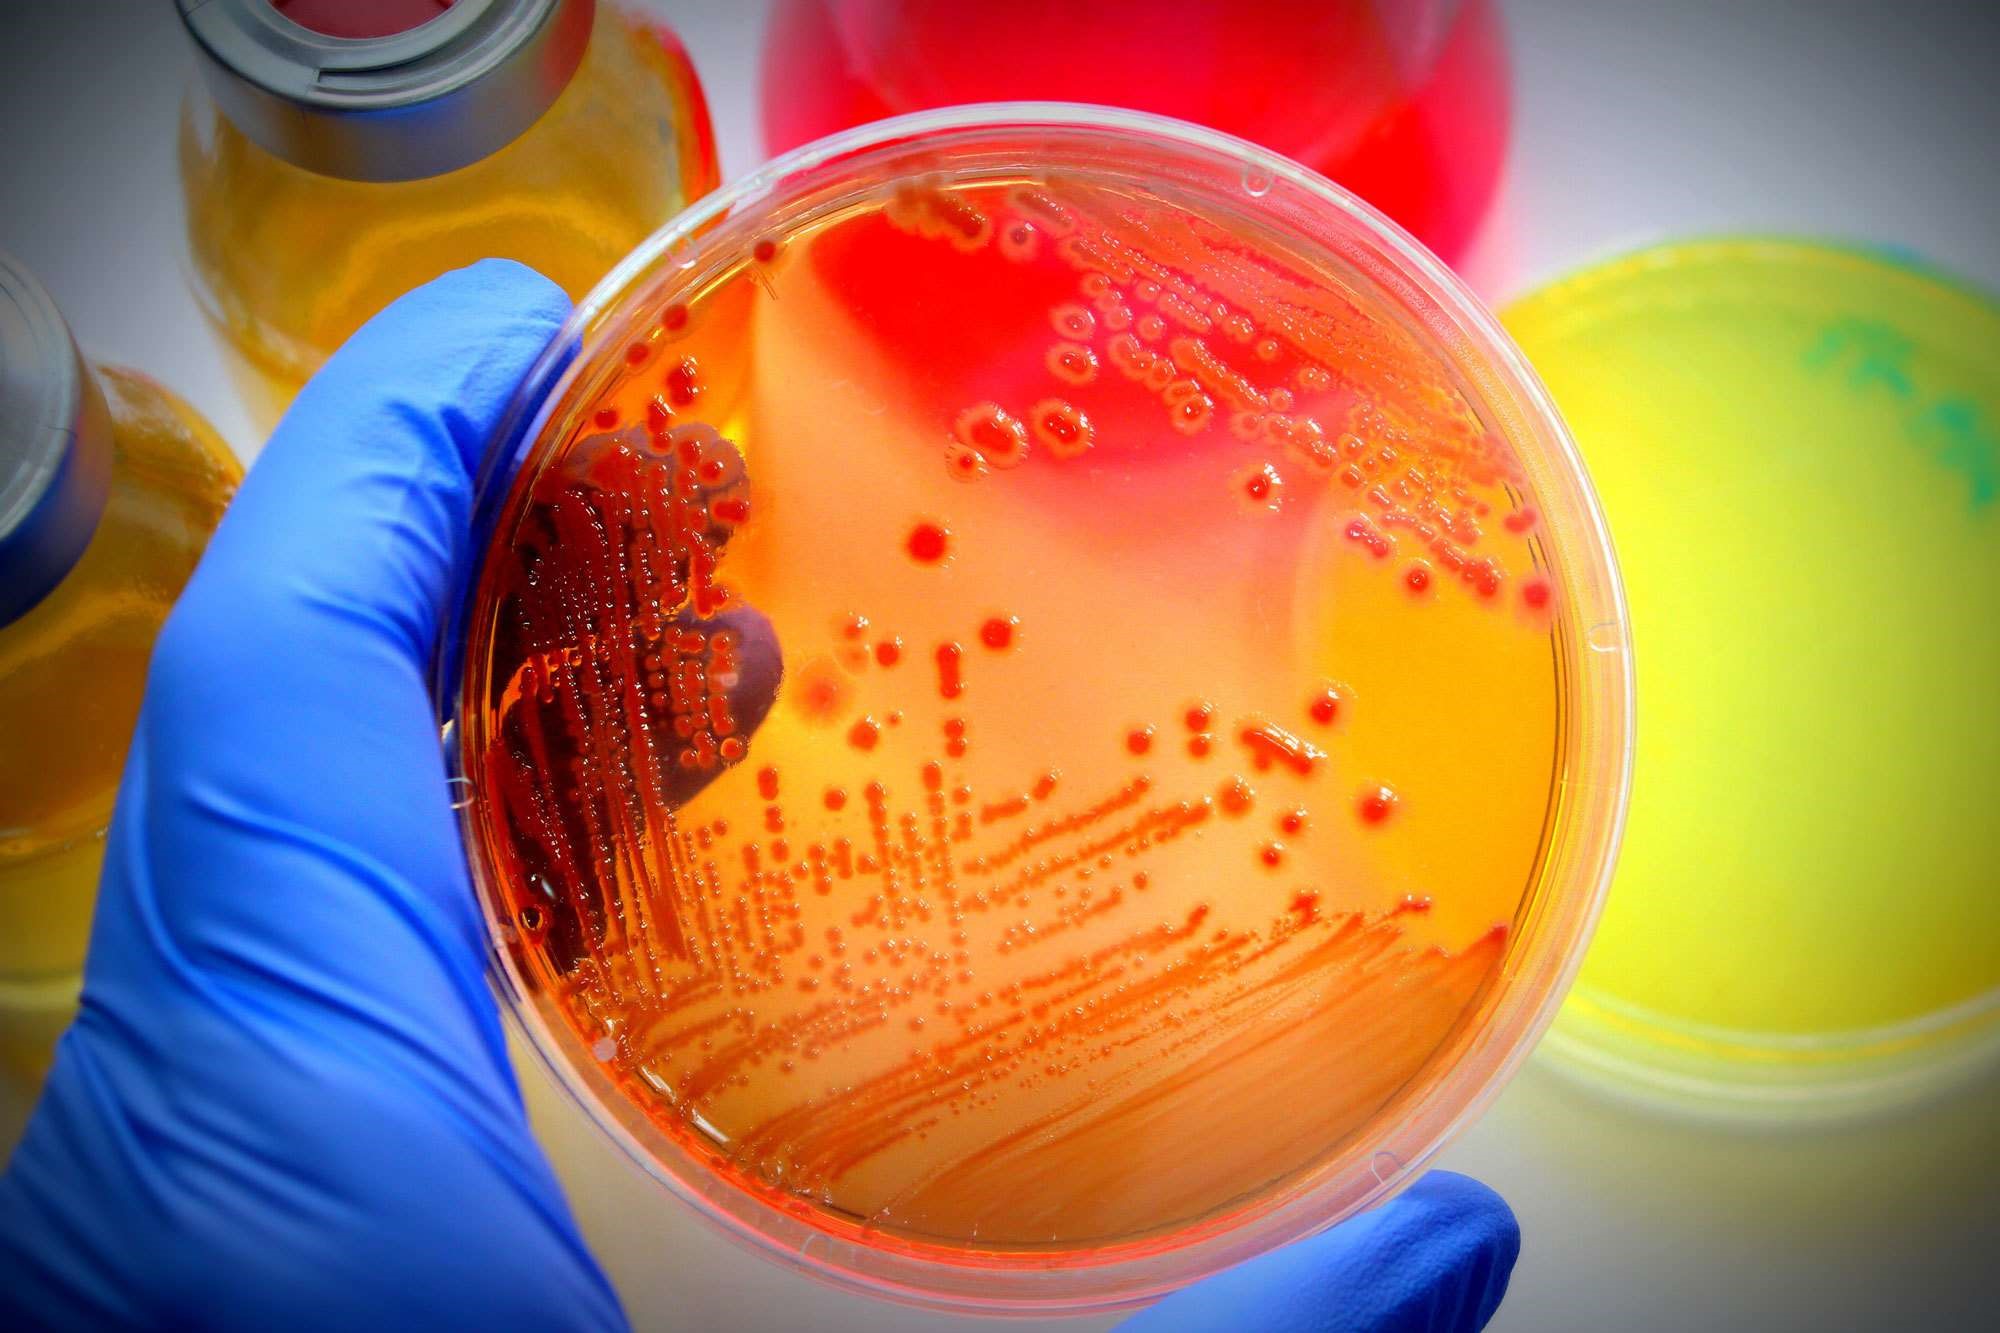
معرفی انواع محیط کشت سلولی و میکروبی

شرکت های معتبر تجهیزات پزشکی - فروشگاه تجهیزات پزشکی
امروزه مراکز درمانی متعدد در سطح کشور نظیر بیمارستان ها، درمانگاه ها و جمعیت کثیری از پزشکان و حتی مشتریان خانگی نیازمند تجهیزات پزشکی می باشند. تجهیزات پزشکی به دلیل آن که با جان مردم سر و کار دارد بایستی از استاندارد های لازم برخوردار بوده تا بتواند سلامت جامعه را تامین نماید. اداره کل تجهیزات پزشکی در این راستا سعی نموده است تا با معرفی تولیدکنندگان، توزیع کنندگان و وارد کنندگان لوازم مصرفی پزشکی از سو استفاده ی افراد و شرکت های نامعتبر جلوگیری نماید.
چرا که غیر استاندارد بودن لوازم پزشکی و یا دستگاه های پزشکی می تواند خطای پزشکان، متخصصین و مراکز درمانی را بالا برده و موجب پایین آمدن سطح بهداشت و سلامت در جامعه شود. لزوم توجه به این مهم همچنین باعث شده است تا این سازمان لیستی از قیمت های مصوب برای فروش تجهیزات پزشکی نیز ارائه نماید که به این طریق مصرف کنندگان خانگی و دیگر ارگان ها بتوانند از قیمت واقعی اجناس اطلاع پیدا کرده و مجبور نباشند که آن ها را با قیمت های گزاف از توزیع کنندگان غیر معتبر خریداری نمایند.
شرکت سدان مد با 15 سال سابقه ی فعالیت در زمینه ی تجهیزات پزشکی، امروزه با گسترش فعالیت های خود در زمینه ی تامین تجهیزات پزشکی تهران و نیز شهرستان ها اهتمام ورزیده است. از جمله اقدامات مفید این شرکت در راستای تامین نیاز های اساسی مردم به تجهیزات پزشکی شامل تجهیز کردن بیمارستان ها، تجهیز کردن کلینیک ها، تجهیز درمانگاه های عمومی و تخصصی، تجهیز آمبولانس، تجهیز درمانگاه های پتروشیمی و سکو های نفتی و نیز کشتی ها و ناوگان های حمل و نقل را می توان نام برد.
فعالیت های مفید این شرکت به همین جا خاتمه نمی یابد، چرا که سدان مد بزرگ ترین شرکت پزشکی می باشد که با اکثر ارگان ها و سازمان های کشور همچون سازمان امداد و نجات، سازمان ملل، هلال احمر، شهرداری، نیروی دریایی سپاه، مپنا و ... همکاری نموده است.
لوازم مصرفی پزشکی
یکی از انواع لوازم مصرفی پزشکی، لوازم مصرفی جراحی می باشد که شامل کامفیل، نخ بخیه، استپلر، ماسک سه لایه ، تروکار، لوله تراشه، کلیپ اپلایر، مش جراحی، کلیپس جراحی، بند لیگاتور، الکترو سرجری، سوند ها و ... بوده که مورد نیاز مراکز درمانی همچون بیمارستان ها می باشد.
این لوازم مصرفی پزشکی به دلیل حساسیت بالا بایستی حتما از بهترین برند ها باشند تا بتوانند سلامت بیماران را حفظ کرده و برای ادامه ی زندگی آنان مشکل ساز نباشد. سدان مد مرجع تخصصی کالای پزشکی می کوشد تا با تمرکز و تخصص لازم در این حوزه، فعالیت های خود را جهت ارتقا کیفیت و سطح سلامت و ایمنی کالای مصرفی پزشکی گسترش داده و در تمام مراحل درمان بیماری، همراه بیماران باشد.
این شرکت تلاش دارد تا بیماران یا مصرف کنندگان خانگی برای تامین نیاز های خود به لوازم پزشکی سختی و مرارت را تحمل نکرده و با تامین سریع وسایل مورد نیاز ایشان، کمی از مشکلات بیماری آنان بکاهد. همچنین فروشگاه تجهیزات پزشکی سدان مد با عرضه ی محصولات استومی، باند و گاز، پانسمان و ... با برند های مختلف و قیمت های متفاوت سعی می کند تا نیاز های مصرف کنندگان را با هر سطح توان مالی به بهترین شکل ممکن برطرف نماید.
علاوه بر این خرید و فروش تجهیزات پزشکی نو و دست دوم نیز از دیگر فعالیت های این شرکت برای تامین نیاز های مراکز درمانی می باشد. سدان مد در نظر دارد تا با فروش تجهیزاتی نظیر دستگاه های پزشکی به صورت نو و دست دوم موجبات رضایتمندی سازمان ها و ارگان های پزشکی را با وسعت هر چه تمام تر فراهم نماید. این شرکت با فروش تجهیزات دست دوم مرغوب و با کیفیت سطح توان مالی ارگان های دولتی را نیز در نظر گرفته و برای تامین نیاز های قشر محروم جامعه نیز از هیچ تلاشی فروگذار نکرده است.
فروشگاه تجهیزات پزشکی
از آن جایی که جستجو برای محصول مورد نظر در بازار و خرید آن می تواند کاری سخت و طاقت فرسا باشد که زمان و انرژی زیادی را از شما صرف می کند، امروزه فروشگاه های اینترنتی خرید مردم را بسیار آسان نموده اند. در میان فروشگاه های اینترنتی تجهیزات پزشکی، فروشگاه تجهیزات پزشکی سدان مد امان خرید تجهیزات پزشکی را به صورت آنلاین برای تمامی هم وطنان عزیزمان در تمام نقاط ایران فراهم نموده است.
شما می توانید لیستی از تمامی محصولات با برند های مختلف را در این فروشگاه به صورت موردی بررسی کرده و ویژگی های هر محصول را به صورت دقیق در این فروشگاه اینترنتی مطالعه نموده و سپس در صورت تمایل اقدام به خرید نمایید. علاوه بر این، فروشگاه اینترنتی تجهیزات پزشکی سدان مد امکان پرداخت درب منزل را نیز برای خریداران تهرانی فراهم نموده است. محصولات در این شرکت در تمامی شاخه های پزشکی همچون تجهیزات و دستگاه های پزشکی بیمارستانی، کلینیکی، مراقبت بیمار در منزل، تجهیزات امداد و نجات و آمبولانس و نیز لوازم مصرفی پزشکی عمومی و تخصصی ارائه می شوند که خریدی امن و راحت را برای شما امکان پذیر می سازند.
لوازم مصرفی پزشکی می توانند از نوع یک بار مصرف و یا از نوع چند بار مصرف باشند. لوازم یک بار مصرف همانطور که از نام آن نیز پیداست به صورت پکیج های بسته بندی برای جلوگیری از انتقال عفونت ها عرضه و روانه ی بازار می شوند که تنها یک مرتبه قابل استفاده می باشند. این محصولات شامل لباس های یک بار مصرف بیمارستانی، چسب های ضد حساسیت پزشکی، انواع دستکش های یکبار مصرف، گان و شان، سرنگ، آبسلانگ، انواع سوند ها، کلاه بیمار و جراح، سر سوزن، آنژیوکت و ... می باشند که تنها یک بار می توان از آن ها استفاده نمود.
علاوه بر لوازم مصرفی پزشکی، سدان مد تجهیزات پزشکی و محصولات زیبایی را نیز با قیمت و کیفیت مناسب در اختیار مصرف کنندگان قرار دارده و سعی می کند تا روز به روز برند های مختلف موجود در بازار را نیز به مصرف کنندگان خود ارائه نماید. ضمانت اصل بودن کالا، ارسال سریع و قیمت مناسب موجب شده است تا این روز ها سدان مد به یکی از محبوب ترین شرکت های توزیع کننده ی تجهیزات پزشکی بدل شده باشد.